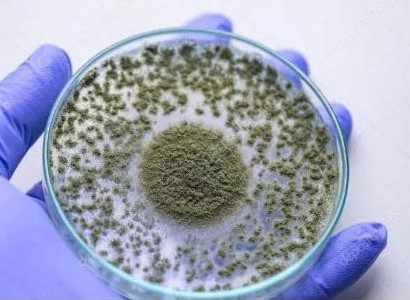

TCVN 14388:2025: Chuẩn hóa phương pháp xác định nấm Aspergillus trong phân bón
(VietQ.vn) - TCVN 14388:2025 góp phần hoàn thiện hệ thống tiêu chuẩn kỹ thuật nhằm xác định và định lượng nấm Aspergillus spp. trong phân bón bằng phương pháp khoa học hiện đại, qua đó nâng cao độ tin cậy của công tác kiểm nghiệm và quản lý chất lượng phân bón tại Việt Nam
Theo phạm vi áp dụng, TCVN 14388:2025 quy định phương pháp định lượng nấm Aspergillus spp. trong phân bón thông qua hai bước chính: Đếm khuẩn lạc (colony-count method) trên môi trường nuôi cấy để xác định số lượng vi sinh vật. Khẳng định bằng phản ứng chuỗi polymerase (PCR) nhằm xác định chính xác chủng nấm thuộc chi Aspergillus.
Sự kết hợp giữa phương pháp nuôi cấy truyền thống và kỹ thuật sinh học phân tử giúp nâng cao độ chính xác trong nhận diện vi sinh vật, hạn chế sai số trong quá trình kiểm nghiệm.
Xác định nấm Aspergillus trong phân bón. Ảnh minh họa
Trong sản xuất phân bón, đặc biệt là phân bón vi sinh, các vi sinh vật được sử dụng có thể mang lại nhiều lợi ích cho cây trồng như phân giải chất hữu cơ, tăng khả năng hấp thụ dinh dưỡng hoặc cải thiện hệ vi sinh đất. Tuy nhiên, nếu không được kiểm soát chặt chẽ, một số chủng nấm có thể gây hại hoặc làm giảm chất lượng sản phẩm.
Chi Aspergillus là nhóm nấm phổ biến trong môi trường đất và vật liệu hữu cơ. Một số loài có thể tham gia quá trình phân giải chất hữu cơ, nhưng một số khác có khả năng sinh độc tố hoặc gây nhiễm tạp trong sản phẩm sinh học. Vì vậy, việc xác định chính xác số lượng và chủng loại nấm trong phân bón là yêu cầu cần thiết đối với các phòng thử nghiệm và cơ sở sản xuất.
Theo quy trình của TCVN 14388:2025, mẫu phân bón được pha loãng và cấy trên môi trường nuôi cấy thích hợp để hình thành các khuẩn lạc. Sau khi ủ trong điều kiện nhiệt độ phù hợp, các khuẩn lạc nghi ngờ thuộc chi Aspergillus sẽ được lựa chọn để thực hiện bước xác nhận bằng PCR. Phương pháp này cho phép nhận diện chính xác DNA đặc trưng của vi sinh vật, từ đó khẳng định sự có mặt của nấm trong mẫu thử.
Kết quả định lượng được biểu thị bằng đơn vị hình thành khuẩn lạc (CFU), tính theo gam đối với mẫu rắn hoặc mililit đối với mẫu lỏng. Công thức tính toán dựa trên số khuẩn lạc đếm được, hệ số pha loãng và thể tích mẫu thử trong quá trình cấy.
Việc chuẩn hóa các bước từ chuẩn bị mẫu, nuôi cấy, quan sát hình thái đến xác nhận bằng PCR giúp đảm bảo tính lặp lại và độ tin cậy của kết quả thử nghiệm giữa các phòng thí nghiệm.
TCVN 14388:2025 nằm trong xu hướng hoàn thiện hệ thống tiêu chuẩn quốc gia đối với phân bón và vật tư nông nghiệp. Cùng với tiêu chuẩn này, nhiều tiêu chuẩn khác cũng được ban hành nhằm xác định các chủng vi sinh vật khác trong phân bón như Penicillium spp., Bacillus laterosporus, Bacillus coagulans hay Bacillus licheniformis.
Việc xây dựng các tiêu chuẩn thử nghiệm vi sinh giúp cơ quan quản lý có cơ sở khoa học để kiểm soát chất lượng sản phẩm lưu thông trên thị trường. Đồng thời, các doanh nghiệp sản xuất phân bón cũng có căn cứ kỹ thuật rõ ràng để kiểm tra nguyên liệu, kiểm soát quy trình sản xuất và đảm bảo sản phẩm đáp ứng yêu cầu kỹ thuật.
Trong bối cảnh nông nghiệp hướng tới phát triển bền vững và ứng dụng công nghệ sinh học, các tiêu chuẩn như TCVN 14388:2025 đóng vai trò quan trọng trong việc bảo đảm tính minh bạch và khoa học của hoạt động thử nghiệm vi sinh. Điều này không chỉ góp phần nâng cao chất lượng phân bón trong nước mà còn tạo nền tảng cho việc hội nhập tiêu chuẩn quốc tế trong lĩnh vực nông nghiệp.
An Nguyên









